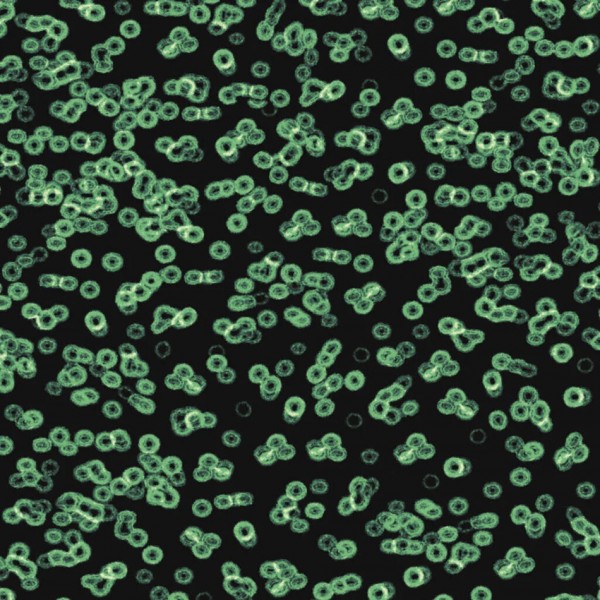

Heimwerkerbedarf > Baumaterialien > Fußböden & Teppichböden
Inhalt: 2 m²
Bitte berechnen Sie 5-10% Verschnitt ein.
Gesamtpreis: ()
Preise inkl. 19% MwSt.; Versandkostenfrei bei Standardversand ab 500 EUR!
Leveringstijd 1-7 Werkdagen, Express-Versand möglich
Forbo Designkollektion Sottsass Bacteria

Zusammen mit seinem Partner Christopher Redfern entwickelte Ettore Sottsass eine eigene Flotex-Kollektion. Sein Verständnis von Design und seine Formensprache bringt er in markanten Dessins zum Ausdruck, die alle ihre eigene Geschichte haben. "Wenn uns etwas retten kann, dann ist es die Schönheit." sagte der Designer, Architekt, Künstler, Fotograf und Schriftsteller einmal. Und zeit seines Lebens brachte der Mitbegründer der "Memphis-Gruppe" die Alltagskultur in seinen Entwürfen spielerisch, lust- und phantasievoll zum Ausdruck.
Flotex Bacteria greift ein Sottsass-Design aus den 70er Jahren auf, das damals primär auf Kunststoff-Möbeloberflächen zum Einsatz kam. Auf Basis seines Lehrmeisters interpretierte es Christopher Redfern neu für den Boden.
| Beanspruchungsbereich: | Klasse 33 Objektbereich stark |
| Trittschallverbesserung: | ΔLw= 21 dB |
| Abmessungen: | Rollenbreite 200 cm / Rollenlänge 30 lfm |
| Gesamtstärke: | ca. 4,3 mm |
| Polmaterial: | 100 % Polyamid 6.6 |
| Fussbodenheizung: | Ja |
| Brandverhalten: | Bfl-s1 |
| Lichtechtheit: | >6 |
| Stuhlrolleneignung: | ISO 4918 - gewerblicher Bereich r ≥ 2,4, Ja |
| Elektrostatische Grenzaufladung: | ≤ 2 kV |
- Technisches Datenblatt zu diesem Artikel
- Verlegeanleitung zu diesem Artikel
- Pflege- u. Reinigungshinweise zu diesem Artikel